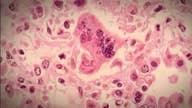
Measles outbreak spreads to 12 states

Congress faster path for legalizing CBD in food, says outgoing FDA chief
The federal government must craft a pathway for CBD use in food given its prior status as an illegal drug.
FDA approves drug for treating postpartum depression
The U.S. Food and Drug Administration has approved the first drug specifically developed for severe depression after childbirth.
The federal government should default on its debt
A soft default is the least bad option. And we ought to bite the bullet now before we rack up even more debt.
5 ways Bernie Sanders-style socialism would hurt the US economy
Sanders and the other socialist sympathizers running for president must be clear-eyed about the limits of the federal bureaucracy that they are all too eager to put in charge of virtually every aspect of American life.
Sanofi working on CEO succession plan: Report
Sanofi has an age limit of 65 for its CEO.
John Boehner flips on pot legalization: Fed laws ‘way out of step’
Legislation to give states more freedom is just around the corner, said Boehner.
Group with consumer-friendly vibe pushes drugmakers' message
Outside groups like the Alliance for Patient Access are raising their voices as they seek to influence deliberations in Washington aimed at lowering prescription drug costs.
Apple Watch detects irregular heart beat in large US study
The Apple Watch was able to detect irregular heart pulse rates that could signal the need for further monitoring for a serious heart rhythm problem, according to data from a large study funded by Apple.
Is the GOP on the right track to revamping Medicaid?
The GOP is proposing major changes to revamp Medicaid, but are they heading in the right way?
Butterball recalls ground turkey after 4 salmonella cases
Butterball LLC is voluntarily recalling more than 78,000 pounds of raw ground turkey products nationwide as Wisconsin health officials investigate four salmonella cases in the state.
Time is just right for moving more Americans from welfare to work
Research shows that work requirements for welfare recipients who are able to work have powerful impacts on those receiving benefits, taxpayers and the economy.
Jury awards $29M in J&J baby powder cancer case
The company has insisted that its talc-based products are demonstrably safe.
No dental insurance? Discount plans can provide savings
No dental insurance?
Fiat Chrysler recalling nearly 900,000 vehicles on emissions
Fiat Chrysler is voluntarily recalling 862,520 vehicles in the U.S. because they don't meet the country's emission standards.
Amazon removes books that promoted an autism 'cure'
Amazon has removed books from its website that promoted "cures" for autism, the latest major company to try to limit the amount of misinformation related to autism and the bogus notion that it's caused by vaccines.
FDA moves to ban sales of flavored e-cigs
The move comes ahead of Commissioner Gottlieb's departure from the agency.
EU check of Polish slaughterhouses finds document issues
Poland's agriculture minister says that a European Commission's veterinary inspection has revealed irregularities in documents at slaughterhouses, but found no problems with the quality of the meat.
Measles outbreak spreads to 12 states
Measles outbreak
Honda recalls 1.2M more vehicles with dangerous air bags
Honda is recalling about 1.2 million vehicles in North and Central America because their Takata air bag inflators can explode and send shrapnel into the passenger compartment.
Trump's cuts to Medicare hospital payments trigger an outcry
As a presidential candidate, Donald Trump pledged not to cut Social Security, Medicare, or Medicaid.